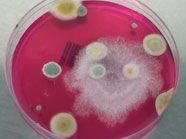

Das behaupten Forscher der University of Cincinnati in der Zeitschrift “Annals of Allergy, Asthma & Immunology”. Ihre Studie bringt Schimmel im Kleinkindalter mit der chronischen Entzündung der Lungenwege und deren Symptome in Verbindung, kann jedoch noch keinen direkten Zusammenhang beweisen.
Gefahr steigt
Die Wissenschaftler um Tiina Reponen untersuchten die Wohnungen von 176 vorbelasteten Kindern – zumindest ein Elternteil hatte eine bekannte Allergie – auf Schimmel oder Modergeruch. Sie entnahmen dabei auch Staubproben aus den Räumen, in denen die Kinder am häufigsten spielten, und stellten per DNA-Test die genauen Schimmelarten fest. 18 Prozent der Kinder, die als Einjährige in einer Schimmelumgebung lebten, litten mit sieben Jahren an Asthma – doppelt so häufig wie jene aus schimmelfreien Wohnungen.
Auslöser und Verstärker
“Schimmel kann zwei denkbare Folgen haben: Bei manchen Menschen löst er selbst eine klassische Allergie aus, die teils spezifisch gegen gewisse Schimmelarten ist und teils unspezifisch gegen mehrere. Weiters kann Schimmel auch die Reaktion auf andere Allergieauslöser wie etwa Pollen verstärken”, erklärt Horst Olschewski, Präsident der Österreichischen Gesellschaft für Pneumologie im pressetext-Interview. Warum dieser Zusammenhang besteht, weiß man bisher nicht. Wenn sich das Ergebnis der US-Forscher in weiteren Erhebungen bestätigt, könnte das in den Augen des Grazer Lungenmediziners eine Fachdiskussion in Gang setzen. “Es wäre eine Gegenhypothese zur weit verbreiteten Annahme, dass der Kontakt im frühen Kindesalter mit allergenen Substanzen zur Toleranz gegen diese beiträgt und Asthma vermeiden hilft.”
Belüften und Heizen wichtig
In jedem Fall empfiehlt Olschewski die Vermeidung von Schimmelbildung in Wohnräumen. Nötig ist dafür die richtige Abstimmung von Luftfeuchte und Raumtemperatur durch ausreichende Belüftung und Heizung sowie die Beseitigung von Kältebrücken durch adäquate thermische Isolierung (pressetext.com)